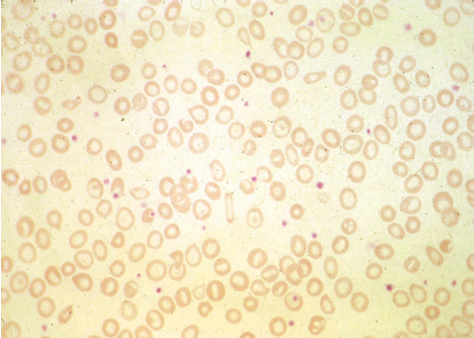

List three causes of microcytic anaemia.
What is anisopoikilocytosis and which type of anaemia is it associated with?
What are tear drop cells and elliptocytes associated with?
What is basophilic stippling? List some causes.
Basophilic appearance of red blood cells caused by the presence of aggregated ribosomal material

Which condition do hypersegmented neutrophils tend to be present in?
Megaloblastic anaemia - reflects impaired DNA synthesis

Hypersegmented is >5 segments
List some causes of megaloblastic anaemia.
In which conditions might you see target cells (codocytes)?

NOTE: target cells have a high SA: V ratio
What are Howell-Jolly bodies? Which condition are they associated with?

Target cells and Howell-Jolly bodies = hyposplenism
List some causes of iron deficiency.
Can occur in combination
List some causes of B12 and folate deficiency.
List some causes of hyposplenism.
Absent spleen
Poorly-functioning spleen
Why ALP is raised in bone turnover?
Released by active osteoblasts
What are some causes of vitamin D deficiency?
Which deficiencies are typically seen in Coeliac disease?
Which deficiencies are typically seen in Crohn’s disease?
Affecting absorption in the terminal ileum
Which deficiencies are typically seen in pancreatic disease?
Which investigations are typically performed in Coeliac disease?
Which HLA alleles are particularly common in patients with coeliac disease?
Describe the T cell response to gluten in coeliac disease.
Describe the B cell response to gluten in coeliac disease.
What are the 2 most sensitive and specific antibodies used to test for coeliac disease?
Anti-gliadin antibodies are not very sensitive nor specific
What important test should be performed before checking anti-tTg and anti-endomysial antibody levels?
IgA levels - IgA deficiency can produce false-negative results
Should you do endoscopy with duodenal biopsy even if coeliac serology is positive?
Yes - need to confirm diagnosis & take histological baseline
What are the characteristic histological features of coeliac disease?
